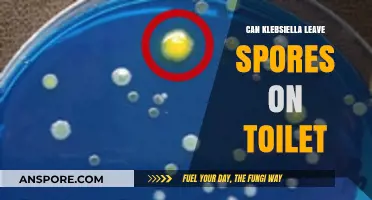
Can Klebsiella Leave Spores on Toilet Surfaces? Facts Revealed

Leather boots, while durable and stylish, are susceptible to mold growth under certain conditions, particularly when exposed to moisture and humidity. Mold spores, which are omnipresent in the environment, can settle on damp leather surfaces and thrive in the absence of proper ventilation and care. Factors such as storing boots in damp areas, wearing them in wet conditions without drying them thoroughly, or neglecting regular cleaning can create an ideal environment for mold to develop. Understanding how mold spores interact with leather and implementing preventive measures are essential to maintaining the longevity and appearance of leather boots.
| Characteristics | Values |
|---|---|
| Can Leather Boots Get Mold Spores? | Yes, leather boots can get mold spores. |
| Conditions for Mold Growth | High humidity, warmth, and lack of ventilation. |
| Common Causes | Exposure to damp environments, improper storage, and prolonged moisture contact. |
| Signs of Mold on Leather Boots | Musty odor, discoloration, white or green spots, and a fuzzy or slimy texture. |
| Prevention Methods | Store in a cool, dry place; use silica gel packets; apply leather conditioner; avoid prolonged exposure to water. |
| Treatment Options | Clean with a mixture of water and vinegar, use a soft brush, and allow to dry completely. For severe cases, consult a professional leather cleaner. |
| Long-Term Effects of Mold | Deterioration of leather, loss of structural integrity, and permanent staining. |
| Health Risks | Allergic reactions, respiratory issues, and skin irritation for sensitive individuals. |
| Frequency of Inspection | Regularly check boots, especially after exposure to moisture or storage in humid areas. |
| Material Susceptibility | Natural leather is more prone to mold compared to synthetic materials due to its organic nature. |
Explore related products
What You'll Learn
- Conditions for Mold Growth: High humidity, warmth, and dampness create ideal environments for mold spores to thrive
- Prevention Tips: Keep boots dry, store in cool, ventilated areas, and use silica gel packets
- Cleaning Moldy Boots: Gently brush off spores, wipe with vinegar solution, and air dry completely
- Leather Susceptibility: Natural leather absorbs moisture, making it more prone to mold compared to synthetic materials
- Long-Term Storage: Condition leather before storing, avoid plastic bags, and inspect boots periodically for mold signs

Conditions for Mold Growth: High humidity, warmth, and dampness create ideal environments for mold spores to thrive
Leather boots, while durable and stylish, are not immune to the threat of mold spores. Mold thrives in environments where humidity levels exceed 60%, temperatures hover between 68°F and 86°F (20°C and 30°C), and surfaces remain damp for prolonged periods. These conditions allow mold spores, which are omnipresent in the air, to settle, germinate, and spread. For leather boots, this often occurs when they are stored in damp basements, left in wet conditions after use, or exposed to high humidity without proper ventilation. Understanding these triggers is the first step in preventing mold growth.
To combat mold, start by controlling humidity levels in storage areas. Use dehumidifiers to maintain indoor humidity below 50%, especially in closets or rooms where boots are kept. After wearing leather boots in wet conditions, allow them to air-dry naturally in a well-ventilated space, avoiding direct heat sources like radiators or hairdryers, which can warp the leather. Stuffing boots with newspaper can absorb moisture from the inside, speeding up drying time. Regularly inspect boots for signs of mold, such as a musty odor or discolored patches, and address issues immediately.
Comparing leather boots to synthetic materials highlights their unique vulnerability. Unlike synthetic boots, leather is a natural material that retains moisture more readily, providing an organic food source for mold. Synthetic boots, while not entirely mold-proof, are less susceptible due to their non-porous nature. However, leather’s breathability and durability make it a preferred choice for many, provided proper care is taken. Conditioning leather boots with a mold-inhibiting product can create a protective barrier, reducing the risk of spore attachment and growth.
A practical tip for preventing mold is to rotate footwear, especially in humid climates. Avoid wearing the same pair of leather boots daily, as this prevents moisture from accumulating and gives them ample time to dry between uses. For long-term storage, clean boots thoroughly, apply a leather conditioner, and store them in breathable bags or boxes with silica gel packets to absorb excess moisture. In extreme cases, consider using mold-inhibiting sprays designed for leather goods, but always test on a small area first to avoid discoloration. By addressing humidity, warmth, and dampness proactively, leather boots can remain mold-free and extend their lifespan.
Blue Air Purifiers: Effective Solution to Eliminate Mold Spores?
You may want to see also

Prevention Tips: Keep boots dry, store in cool, ventilated areas, and use silica gel packets
Leather boots, while durable and stylish, are susceptible to mold spores if not cared for properly. Mold thrives in damp, dark environments, making improperly stored boots an ideal breeding ground. To prevent this, the first line of defense is keeping your boots dry. After wearing, wipe off any moisture with a soft cloth and allow them to air dry naturally, away from direct heat sources like radiators or hair dryers, which can warp the leather. For wet boots, stuff the insides with newspaper to absorb moisture, replacing it as it dampens. This simple step can significantly reduce the risk of mold taking hold.
Once your boots are dry, proper storage becomes critical. A cool, ventilated area is essential to discourage mold growth. Avoid tightly sealed plastic containers or damp basements, as these environments trap humidity. Instead, opt for a breathable storage solution like a cloth bag or a wooden shoe rack placed in a well-ventilated room. Ensure the area maintains a consistent temperature, ideally between 50°F and 70°F, to prevent condensation. If storing boots long-term, consider using a dehumidifier in the room to maintain optimal conditions.
Silica gel packets are a practical and effective tool in the fight against mold. These small packets absorb excess moisture, keeping the air around your boots dry. Place 2–3 packets inside each boot, particularly during storage, and replace them every 3–6 months or as they become saturated. Silica gel is reusable—simply bake the packets in an oven at 225°F for 2 hours to reactivate them. This cost-effective method complements proper drying and storage, providing an extra layer of protection against mold spores.
While these prevention tips are straightforward, consistency is key. Regularly inspect your boots for signs of moisture or mold, especially after exposure to wet conditions. If mold is detected, address it immediately by cleaning the affected area with a mixture of mild soap and water, followed by thorough drying. By integrating these practices into your boot care routine, you can preserve their quality and extend their lifespan, ensuring they remain mold-free and ready for wear.
How Spores Shield Bacteria: Survival Strategies in Harsh Environments
You may want to see also

Cleaning Moldy Boots: Gently brush off spores, wipe with vinegar solution, and air dry completely
Leather boots, despite their durability, are susceptible to mold spores, especially in damp, humid environments. Mold thrives in moisture-rich conditions, and leather, being a natural material, can absorb and retain water, creating an ideal breeding ground for spores. If left unchecked, mold can not only discolor and weaken the leather but also pose health risks, as mold spores can cause allergic reactions or respiratory issues. Recognizing the signs early—such as a musty odor, white or green spots, or a fuzzy texture—is crucial for effective remediation.
The first step in cleaning moldy boots is to gently brush off visible spores using a soft-bristled brush or cloth. This minimizes the risk of spreading mold to other areas of the boot or into the air. Avoid vigorous scrubbing, as it can damage the leather’s surface. Work in a well-ventilated area or outdoors to prevent inhaling spores. Once the loose spores are removed, inspect the boots closely to ensure no visible mold remains on the surface.
Next, prepare a vinegar solution to disinfect and clean the affected areas. Mix equal parts white vinegar and water in a bowl or spray bottle. Vinegar’s acidic nature effectively kills mold without harming the leather. Dip a clean cloth into the solution, wring it out thoroughly to avoid oversaturating the leather, and gently wipe down the boots, focusing on moldy spots. For stubborn mold, allow the vinegar solution to sit on the leather for 5–10 minutes before wiping it off. Repeat the process if necessary, ensuring all mold is addressed.
After cleaning, proper drying is essential to prevent mold from returning. Air dry the boots completely in a well-ventilated, dry area away from direct heat sources like radiators or hair dryers, as excessive heat can warp or crack the leather. Stuff the boots with crumpled newspaper to absorb moisture from the inside and help maintain their shape. Rotate the boots periodically to ensure even drying. Depending on humidity levels, this process may take 24–48 hours.
To maintain mold-free boots, adopt preventive measures. Store them in a cool, dry place with good airflow, and avoid leaving them in damp environments like basements or garages. Condition the leather regularly to keep it supple and less prone to moisture absorption. If boots are exposed to water, wipe them dry immediately and allow them to air dry naturally. By following these steps, you can effectively clean moldy boots and extend their lifespan while safeguarding your health.
Discovering Timmask Spores: A Comprehensive Guide to Sourcing and Harvesting
You may want to see also
Explore related products

Leather Susceptibility: Natural leather absorbs moisture, making it more prone to mold compared to synthetic materials
Natural leather, a material prized for its durability and aesthetic appeal, has a significant Achilles' heel: its propensity to absorb moisture. Unlike synthetic materials, which are often designed to repel water, leather's porous structure allows it to soak up humidity from its environment. This characteristic, while beneficial for breathability and comfort, creates an ideal breeding ground for mold spores. When leather boots are exposed to damp conditions—whether from rain, sweat, or high humidity—the trapped moisture provides the necessary conditions for mold to thrive. This makes leather boots particularly vulnerable to mold growth, especially if they are not properly cared for after exposure to wet environments.
To mitigate this risk, it’s essential to understand the science behind mold growth. Mold spores are omnipresent in the environment, and they only need three things to flourish: moisture, organic material, and warmth. Leather, being a natural product derived from animal hides, provides the organic material mold craves. When moisture is introduced, the stage is set for mold to take hold. Synthetic materials, on the other hand, lack the organic components that mold requires, making them inherently more resistant. For instance, rubber or vinyl boots can withstand prolonged exposure to moisture without developing mold, whereas leather boots require immediate attention to prevent infestation.
Practical steps can be taken to protect leather boots from mold. After exposure to moisture, thoroughly dry the boots in a well-ventilated area, away from direct heat sources like radiators or hair dryers, which can cause the leather to crack. Stuffing the boots with newspaper can help absorb internal moisture, while a gentle application of leather conditioner once dry will restore suppleness and create a barrier against future moisture absorption. For added protection, store boots in a cool, dry place with silica gel packets to control humidity. Regular maintenance, such as cleaning and conditioning every few months, can significantly reduce the likelihood of mold growth.
Comparing leather to synthetic materials highlights the trade-offs in choosing one over the other. While synthetic boots may be more mold-resistant, they often lack the breathability and comfort of leather. Leather boots, however, require a higher level of care to maintain their integrity. For those who prefer leather, the key is proactive management. Investing in a waterproof spray designed for leather can provide an additional layer of defense, though it’s important to reapply every few months, especially after cleaning. By understanding leather’s susceptibility to moisture and taking preventive measures, owners can enjoy the longevity and beauty of their boots without falling victim to mold.
In conclusion, the natural properties of leather make it inherently more susceptible to mold compared to synthetic materials. However, with proper care and maintenance, this risk can be effectively managed. By addressing moisture promptly, using appropriate conditioning products, and storing boots in optimal conditions, leather enthusiasts can preserve their footwear while minimizing the threat of mold. The choice between leather and synthetic materials ultimately depends on the wearer’s priorities, but for those who value the timeless appeal of leather, a little extra effort goes a long way in ensuring its durability.
Can Darkspore Still Be Played? Exploring the Game's Current Status
You may want to see also

Long-Term Storage: Condition leather before storing, avoid plastic bags, and inspect boots periodically for mold signs
Leather boots, when stored improperly, can become a breeding ground for mold spores. These microscopic fungi thrive in damp, dark environments, and untreated leather provides the perfect organic material for their growth. Before stowing your boots away for the season, conditioning the leather is crucial. Use a high-quality leather conditioner to replenish natural oils, creating a barrier against moisture absorption. Apply a thin, even layer, allowing it to penetrate the material for at least 20 minutes before wiping off excess. This step not only preserves the leather’s suppleness but also reduces the risk of mold by minimizing cracks and dryness where spores can take hold.
Plastic bags, though seemingly protective, are a common mistake in long-term boot storage. They trap moisture, creating a humid microclimate ideal for mold growth. Instead, opt for breathable materials like cotton or linen dust bags, or store boots in a well-ventilated area on a wooden shoe rack. Ensure the storage space maintains a consistent temperature between 60–70°F (15–21°C) and humidity below 50%. If your climate is particularly damp, consider using silica gel packets or a dehumidifier to control moisture levels. Proper airflow is key—never stack boots tightly together, as this restricts ventilation and increases the likelihood of mold.
Periodic inspection is non-negotiable for long-term storage. Every three months, retrieve your boots and examine them for early signs of mold, such as a musty odor, discolored patches, or a fuzzy texture. If detected, address the issue immediately. Gently clean the affected area with a mixture of equal parts water and white vinegar, using a soft-bristled brush to avoid damaging the leather. After cleaning, recondition the leather and reassess your storage conditions. Neglecting this step can lead to irreversible damage, as mold spores can penetrate deep into the material, weakening its structure and ruining the boot’s appearance.
Comparing proper storage practices to common mistakes highlights the importance of proactive care. For instance, while plastic bags are often chosen for their perceived protective qualities, they ultimately create conditions conducive to mold. Conversely, breathable storage solutions and regular maintenance not only prevent mold but also extend the lifespan of your boots. Think of it as an investment—a few minutes of conditioning and inspection every few months can save you from costly repairs or replacements down the line. By treating your leather boots with the care they deserve, you ensure they remain a durable and stylish staple for years to come.
Vascular Plants: Exploring Reproduction via Spores and Seeds
You may want to see also
Frequently asked questions
Yes, leather boots can get mold spores, especially in damp, humid, or poorly ventilated environments where moisture accumulates.
Mold spores develop on leather boots when they are exposed to moisture for prolonged periods, creating a damp surface where spores can settle, grow, and multiply.
Signs of mold on leather boots include a musty odor, discoloration (often green, black, or white patches), and a fuzzy or powdery texture on the surface.
To prevent mold, keep your boots clean and dry, store them in a cool, dry place with good airflow, and use a leather conditioner to maintain the material's integrity.